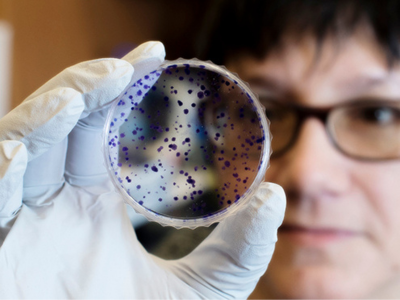

We are UAB Neurosurgery
Celebrating 10 years of serving our state and region
This year marks a significant milestone in the UAB Department of Neurosurgery’s history – the 10th anniversary of the department’s elevation from division to department.
The UAB Department of Neurosurgery was initially founded in 1954 by James Garber Galbraith, M.D., as the UAB Division of Neurosurgery within the Department of Surgery. It was not until Oct. 1, 2013, that the Department of Neurosurgery became the 24th academic department in the UAB Heersink School of Medicine. James M. Markert, M.D., MPH, who was recruited to UAB in 1995, served as the director of the Division of Neurosurgery from 2006 until 2013 when he became the inaugural chair of the Department of Neurosurgery.
The department now serves UAB Hospital, Children's of Alabama, Medical West, The Kirklin Clinic, UAB Highlands and the Birmingham Veteran's Administration Hospital, and performs more than 4,000 procedures annually. Today, neurosurgeons and residents within the department aspire to continue the traditions of clinical excellence, honorable conduct and dedication to their patients and residents, which the department has exemplified since its inception.
Celebrating 10 golden years
To mark this momentous anniversary, we intend to celebrate all year! Events, giveaways and opportunities to reflect on the past ten years will roll out each month - including the news feed below that will highlight archived department stories. Each month leading up to our 10-year anniversary in October, pivotal stories from the past ten years will be showcased. We hope this year-by-year historical catalog inspires pride in our accomplishments and energizes us for the future ahead!
WHO adopts first neurosurgical-initiated resolution
The World Health Organization (WHO) recently announced its adoption of a resolution urging countries to implement large scale food fortification, marking a milestone for the spina bifida community globally.
UAB Medicine adds surgery suite with built-in MRI
UAB Hospital opened a new surgical suite, the first in Alabama, with the ability to take MRI images while the surgery is underway, allowing surgeons to see images in real time as an operation is progressing.
UAB does first radiofrequency ablation for epilepsy in Alabama
In 2022, neurosurgeons with the University of Alabama at Birmingham performed the first radiofrequency ablation for epilepsy in Alabama.
UAB-developed algorithm may predict the onset of seizure clusters
Researchers at the University of Alabama at Birmingham developed a method to predict when patients with seizure disorders such as epilepsy might be at risk for a cluster of seizures.
UAB joins study to slow bleeding in the brain
In 2022, researchers at the University of Alabama at Birmingham joined an international study investigating a drug that could potentially stop or slow intracerebral hemorrhage.
Virtual Reality and Neurosurgery: The new training frontier
The University of Alabama at Birmingham Department of Neurosurgery enhanced neurosurgical resident education and training using virtual reality.
UAB-developed viral immunotherapy for pediatric brain tumors shows promise
According to findings from researchers at the University of Alabama at Birmingham and Children’s of Alabama, a modified herpes virus was shown to be well tolerated with early signs of clinical effectiveness in pediatric glioma patients.
UAB CNBCI named a pilot UWIRC
In 2021, the University of Alabama at Birmingham took major steps in the field of neuroengineering by establishing the Center for Neuroengineering and Brain Computer Interfaces, which was named a pilot University-Wide Interdisciplinary Research Center.
UAB joins research network dedicated to improving treatments for brain tumors
In 2021, the University of Alabama at Birmingham was named a co-site on a $30 million NIH grant to improve treatments for patients with glioblastoma, the most common and aggressive primary brain tumor in adults.
UAB Adult Spina Bifida Clinic designated as Clinic Care Partner
The Spina Bifida Association recognized the UAB Adult Spina Bifida Clinic as a Clinic Care Partner, making it one of the initial recipients of this distinction.
UAB begins offering LITT for epilepsy treatment
The University of Alabama at Birmingham and Children’s of Alabama were the first institutions in Alabama to offer the innovative epilepsy treatment.
UAB patient first in Alabama to get deep brain stimulation for epilepsy
The UAB Department of Neurosurgery made history in February 2019 by treating the first patient in Alabama and the 27th in the nation for epilepsy using deep brain stimulation (DBS).
Inaugural Division of Pediatric Neurosurgery established
Effective October 1, 2019, the Section of Pediatric Neurosurgery within the UAB Department of Neurosurgery was elevated to the status of the inaugural Division of Pediatric Neurosurgery within the department.
UAB Stroke Center joins NIH StrokeNet
In an effort to fill a gap in stroke care in the Deep South, UAB joined the National Institutes of Health StrokeNet under a $1 million grant from the National Institute of Neurological Disorders and Stroke.
UAB develops Spina Bifida Individualized Care Model
The UAB Transitional Spina Bifida Clinic developed the Individualized Care Model for Transitional Care in Spina Bifida to address the unique needs of spina bifida patients during their transition from pediatric to adult healthcare.
UAB makes history in brain cancer treatment
The University of Alabama at Birmingham made history when its Department of Neurosurgery became the first in the U.S. to utilize HyperArc High-Definition Radiotherapy for the treatment of brain cancer.
Department of Neurosurgery makes history at COA
The UAB Department of Neurosurgery Division of Pediatric Neurosurgery made history Robin Struble became the first patient at Children’s of Alabama to undergo thermal laser ablation surgery as an epilepsy treatment.
UAB Opens Greystone Neurosurgery Clinic
The UAB Department of Neurosurgery made advanced neurosurgical care more accessible than ever by opening the Greystone Neurosurgery Clinic.
UAB earns Comprehensive Stroke Center designation
The UAB Department of Neurosurgery was recognized as an industry leader in stroke care by receiving the Comprehensive Stroke Center designation by the Joint Commision and American Heart Association/American Stroke Association.
Neurosurgery elevated to department status
The UAB Department of Neurosurgery became the 24th academic department in the UAB Heersink School of Medicine on Oct. 1, 2013, after the Board of Trustees of the University of Alabama System approved the measure.
Markert receives $2.8 million R01 grant
James Markert, M.D., MPH, recently received a $2.8 million R01 grant from the National Cancer Institute for his project in collaboration with Anna Sorace, Ph.D.

Sincerely,